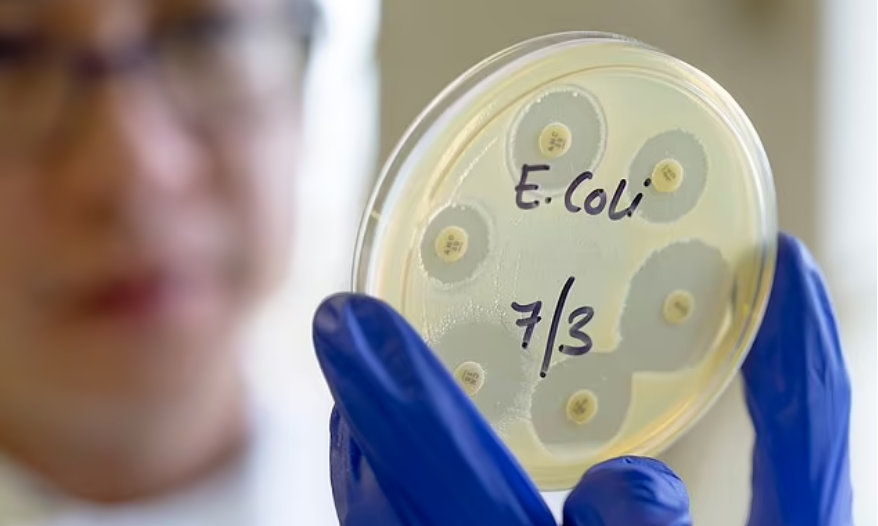
vacina

Entre nos nossos canais do Telegram e WhatsApp para notícias em primeira mão.

Uma vacina revolucionária que destrói cepas específicas da bactéria E. coli pode reduzir o risco de câncer de intestino, bexiga e próstata, segundo cientistas.
Pesquisas sugerem que o aumento dos casos de certos tipos de câncer pode estar ligado à bactéria, conhecida por causar intoxicação alimentar, infecções do trato urinário e infecções sanguíneas.
As cepas particularmente perigosas produzem uma substância química danificadora do DNA chamada colibactina, que foi associada a vários tipos de câncer, incluindo o câncer de intestino.
Vacinar as pessoas para prevenir a infecção poderia oferecer “enormes benefícios para a saúde pública”, incluindo a redução do risco de câncer, disseram os pesquisadores.
O aumento acentuado de jovens diagnosticados com câncer é uma tendência que está deixando os médicos perplexos.
O câncer colorretal é o quarto tipo mais comum no Brasil, ficando atrás apenas do câncer de pele não melanoma, mama e próstata. Segundo o Instituto Nacional do Câncer (Inca), são estimados 45.630 casos da doença no país a cada ano do triênio 2023-2025.
Acredita-se que o aumento misterioso esteja ligado à obesidade, sedentarismo e consumo de alimentos não saudáveis.
Os casos de câncer de próstata também aumentaram 622% em pessoas de 25 a 49 anos desde o início da década de 1990, e mais de 55.000 casos são diagnosticados por ano no Reino Unido em todos os grupos etários, segundo o Cancer Research.
Embora os casos gerais de câncer de bexiga tenham diminuído 23% no Reino Unido entre 2000 e 2002, mais de 10.000 pessoas são diagnosticadas com a doença todos os anos, segundo o Cancer Research.
Mas uma vacina para combater a E. coli, um grupo diverso de bactérias que normalmente são inofensivas e vivem nos intestinos de humanos e animais, poderia reduzir esses números, revelou um estudo publicado na revista Lancet Microbe.
No estudo, os pesquisadores usaram dados de vigilância internacional para rastrear diferentes cepas que infectaram pacientes em vários países, incluindo o Reino Unido, Noruega, Paquistão e Bangladesh.
Os acadêmicos estavam especialmente interessados em duas cepas que são mais comuns em países industrializados e causam infecções do sangue e do trato urinário, em vez do sistema digestivo.
Esses países também têm níveis mais altos de câncer de intestino, bexiga e próstata, segundo os pesquisadores.
A análise da equipe mostrou que essas cepas eram muito mais raras em países como Bangladesh e Paquistão, onde os casos de câncer de intestino, bexiga e próstata também são menores.
O autor sênior, Professor Jukka Corander, do Wellcome Sanger Institute, da Universidade de Oslo e da Universidade de Helsinque, disse: “Usamos genômica em larga escala para rastrear cepas de E. coli em vários países nos últimos cinco anos, usando dados que remontam ao início dos anos 2000.”
“Isso nos permitiu começar a ver as possíveis conexões entre duas cepas de E. coli e as taxas de incidência de câncer.”
Pesquisas anteriores ligaram a substância química danificadora do DNA chamada colibactina, produzida por certas cepas de E. coli, a vários tipos de câncer.
Os pesquisadores observam que um estudo de 2020 mostrou que amostras de tumor coletadas de pacientes com câncer colorretal tinham mutações que apresentavam sinais da substância química colibactina.
Outros estudos mostraram que a colibactina pode alimentar o desenvolvimento de câncer de próstata e bexiga.
Os pesquisadores dizem que isso indica uma ligação plausível com um risco aumentado de todos os três tipos de câncer.
Os autores do estudo sugeriram que intervenções que erradicassem essas duas cepas de E. coli, como uma vacina, poderiam ser extremamente eficazes na redução das taxas de câncer.
Outra opção sugerida no estudo é um “probiótico terapêutico” para ajudar a destruir essas duas cepas de E. coli do intestino humano, com o objetivo de eliminá-las completamente da população.
O Dr. Tommi Maklin, da Universidade de Helsinque e do Wellcome Sanger Institute, que trabalhou no estudo, acrescentou: “A E. coli pode ser encontrada em todo o mundo, em muitas formas diferentes, e entender como as cepas dessa bactéria impactam os humanos de maneiras diferentes pode nos dar uma imagem mais completa da saúde e da doença.”
“Ter acesso a dados genômicos globais sobre quais cepas são encontradas em uma área pode revelar novas tendências e possibilidades, como cepas em países industrializados potencialmente ligadas ao risco de certos tipos de câncer.”
“Também precisamos continuar garantindo que países e regiões ao redor do mundo sejam incluídos na pesquisa de vigilância genômica para que todos se beneficiem de novas descobertas.”
O professor Corander disse que espera que as descobertas desbloqueiem uma maneira de potencialmente erradicar a E. coli que produz colibactina, uma substância química que foi ligada ao câncer de intestino.
“A ciência não é um esforço isolado e, trabalhando em conjunto com especialistas em câncer e microbioma, esperamos que, no futuro, esse trabalho possa levar a novas maneiras de erradicar as cepas de E. coli que produzem colibactina”, disse ele.
“Vacinas ou outras intervenções que visam essas cepas de E. coli podem oferecer enormes benefícios para a saúde pública, como reduzir a carga de infecções e diminuir a necessidade de antibióticos para tratá-las, além de reduzir o risco de cânceres que podem estar ligados aos efeitos da exposição à colibactina.”
O Dr. Trevor Lawley, do Wellcome Sanger Institute, disse: “No futuro, pode ser possível desenvolver probióticos terapêuticos que ajudem a deslocar cepas bacterianas indesejadas, como as que liberam colibactina.
“Entender mais sobre as interações entre a E. coli e o risco de câncer destaca o impacto que nosso microbioma tem em nossa saúde e é uma avenida crucial a explorar se quisermos trabalhar com nossos corpos para ajudar a combater certas condições.”